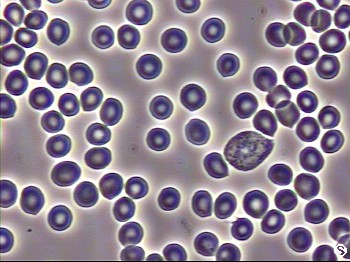

Serenelli's Cancer Experience diary...
Serenelli's Cancer Experience diary...
Live Cell Test - 9 Feb, 2004 Back to index | |
|
Patient Name : Stephen Serenelli Patient ID : 237 Session ID : 1 Session Practitioner : John Michael Drabiuk LCA Information 9 February 2004 |
|
|---|---|

| |
|
This is normal dried capillary blood.
| |

| |
|
This is normal functioning neutrophil involved in phagocytosis.
| |
| |
|
This is perfect capillary sample. The white cell looks good, approx 50% of sample.
| |

| |
|
The fine lines in the foreground are a result of acute dic from oxidative stress.
| |
Copyright © 1993 Serenelli Desktop Publishing. All Rights Reserved.